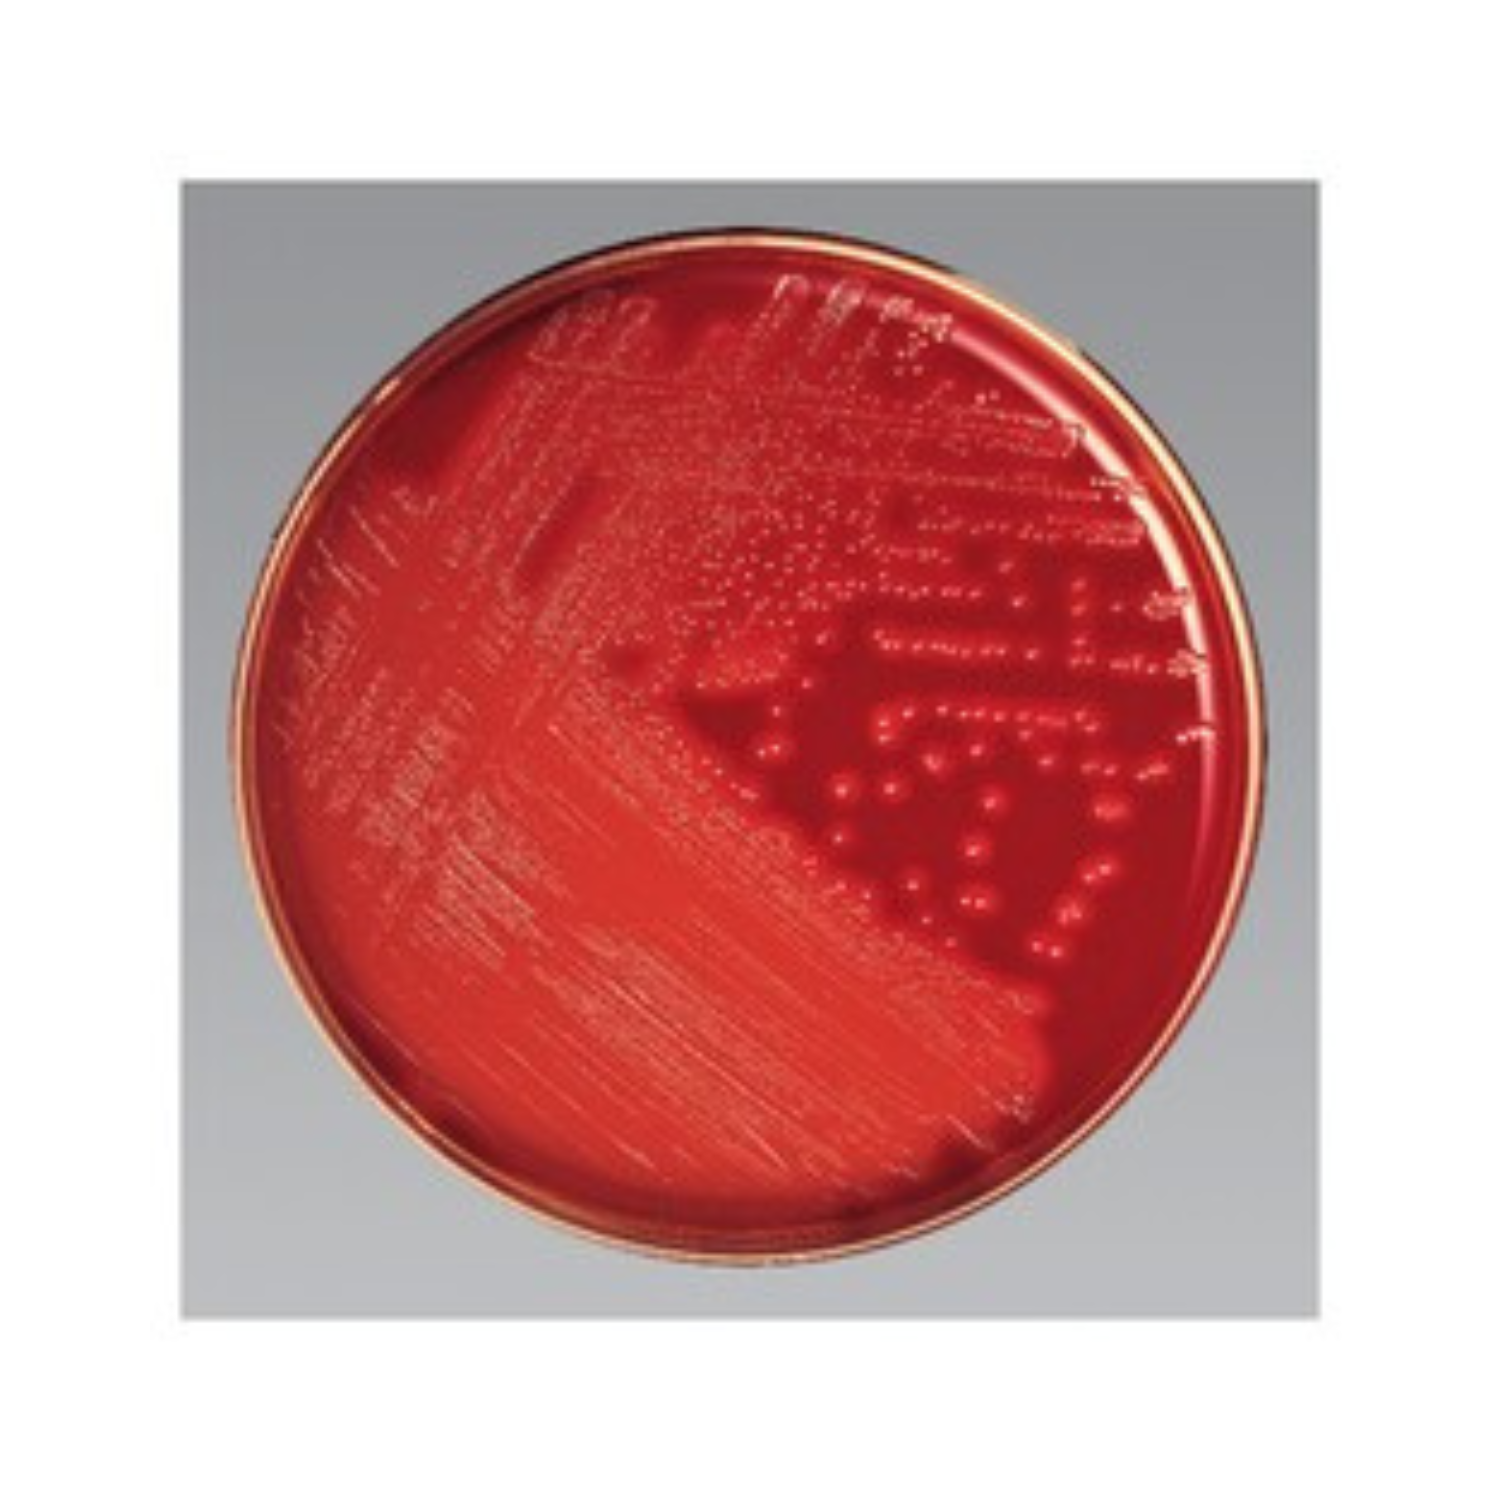
STREP SELECTIVE AGAR 10/PK

STREP SELECTIVE AGAR 10/PK
Isolate and cultivate Streptococcus pyogenes from throat cultures and upper respiratory specimens with this selective, ready-to-use medium.
Isolate and cultivate Streptococcus pyogenes from throat cultures and upper respiratory specimens with Thermo Scientific™ Remel™ Strep Selective Agar prepared plates with RNA, maltose, neomycin, polymyxin B. The medium is based on the formulation of Roantree, Rantz and Haines1. The addition of ribonucleic acid and maltose increases the production of the streptolysin S, the active substance causing hemolysis on blood agar. Neomycin and polymyxin B are selective agents which facilitate isolation of S. pyogenes by suppressing commensal microbial flora found in the oropharynx.
Streptococcus pyogenes is an important human pathogen that causes a wide variety of acute infections, such as soft tissue infections and pharyngitis; severe life-threatening infections, such as streptococcal toxic shock syndrome; and devastating post-infectious sequelae, such as rheumatic fever and glomerulonephritis.
Use Strep Selective Agar with RNA, maltose, neomycin, polymyxin B for the primary isolation of Streptococcus pyogenes from throat cultures and upper respiratory specimens.
- Selective: selective agents neomycin and polymyxin B suppress commensal microbial flora, including coliforms, staphylococci, Micrococcus, Haemophilus, and Neisseria
- Ready-to-use: the convenience of prepared media.
Not all products are available for sale in all territories. Please inquire.
Remel™ and Oxoid™ products are now part of the Thermo Scientific brand.
SPECIFICATION
- Brand: Thermo Scientific
- Catalog No.: R01857
- Description: Strep Selective Agar w/RNA, maltose, neomycin, polymyxin B
- Format: 12mm x 85mm Monoplate
- Product Type: Agar
- Quantity: 10/Pk.